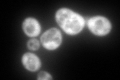
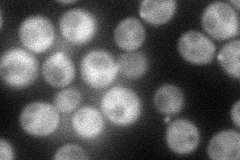
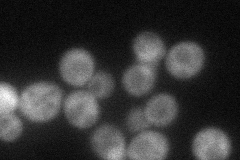
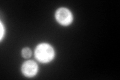
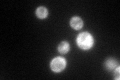

View description
Protein of unknown function, required for survival upon exposure to K1 killer toxin
Localization:
Intensity:
Fold change:
Significance:
-
C’ GFP library in SD
cytosol328.26 -
N' NOP1pr-GFP in SD
cytosol,bud57.6152 -
N' TEF2pr-mCherry in SD
cytosol37.8164 -
N' NATIVEpr-GFP in SD

punctate,bud neck27.0193 -
N' TEF2pr-VC and Cyto-VN in SD

cytosol41.8966 -
C’ GFP library in SD+DTT
cytosol284.250.86No -
C’ GFP library in SD+H2O2

cytosol328.261No -
C’ GFP library in Starvation Media
cytosol171.530.52No -
C’ GFP library on the background of Pup2-DaMP

cytosol -
C’ GFP library on the background of CCT mutant

cytosol402.8481.22719No
